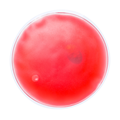
Rot

KISON WÄRMEPACKUNG
Wiederverwendebares Wärme-/ Kühlkissen mit farbiger Gel-Füllung.
- Material: Kunststoff
- Maße: ø100×10 mm
Diesen Artikel können wir auf Ihren Wunsch bedrucken. Einen Kostenvoranschlag können Sie einfach mit einem Klick auf „KOSTENVORANSCHLAG/BRANDING“ anfordern.
Material: Upper: 100% PU polyester - Mesh in 100% polyester.Lining: 100% polyester.Sole: EVA and rubber.
Code: AP781012
Preis ohne MWSt: 2,05 CHF
Preis mit Mehrwertsteuer: 2,05 CHF